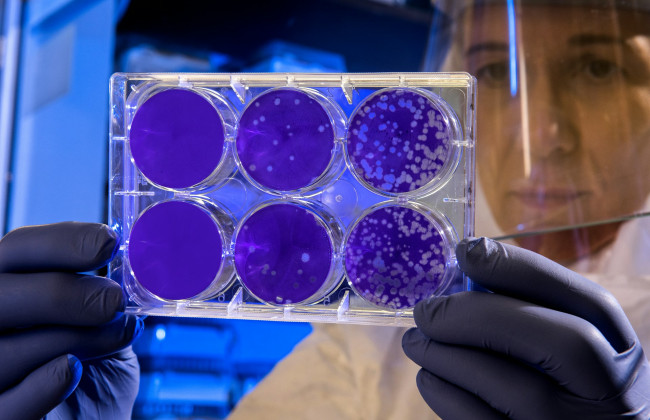
«Болезнь Х» – в Минздраве объяснили, что это такое и как Украина готовится к потенциальной угрозе

«Болезнь Х» – в Минздраве объяснили, что это такое и как Украина готовится к потенциальной угрозе
Многие уже слышали термин «болезнь Х» и даже подумали, что мир снова столкнулся с новой угрозой. Однако в Министерстве здравоохранения заверили, что это не так.
Болезнь Х – это потенциальная угроза, которую ученые всего мира совместно пытаются заранее спрогнозировать, чтобы мгновенно применить все имеющиеся ресурсы для сохранения самого главного – жизни людей.
В свое время пандемия COVID-19 также была болезнью Х. Каждая страна сделала выводы о своих системах здравоохранения и важности международного сотрудничества, обмена данными, технологиями и инновациями.
Украина является частью глобального механизма. Политическое и отраслевое сотрудничество – это то, что позволяет нам всем подготовиться как можно лучше. В частности, речь идет об оперативной разработке высококачественных диагностических, терапевтических средств и вакцин. Сейчас речь идет о 100 днях на случай следующей эпидемии», – отметил министр здравоохранения Украины Виктор Ляшко.
Министр подчеркнул, что есть три компонента, свидетельствующие о готовности системы здравоохранения к вызовам любых эпидемий:
- люди (кадровый потенциал),
- сильная лабораторная сеть, работающая по международным стандартам;
- глобальное партнерство.
Украина развивает каждый из них.
Что касается развития кадрового потенциала, то за последние 5 лет 167 украинских специалистов прошли международные учения по полевой эпидемиологии. Каждый год количество интернов, поступающих на специальность «Эпидемиология», увеличивается. В 2020 году – 14 интернов, в 2022 – 70 человек, отмечает Ляшко.
Одна из самых больших глобальных угроз человечества сейчас — устойчивость к антибиотикам. То есть, когда существующие лекарства перестают действовать. В 2019 году почти 5 миллионов смертей были связаны с антибиотикорезистентностью, более миллиона смертей были непосредственно вызваны ею. Чтобы противостоять этой угрозе, только за последние 2,5 года количество бактериологических лабораторий увеличилось в Украине вдвое — с 37 до 69, усилен дозорный эпиднадзор за антимикробной резистентностью (в том числе у раненых во время войны).
Кроме того, по словам Ляшко, Минздрав тесно сотрудничает с ВОЗ, Центрами контроля и профилактики болезней Европы и США, Управлением Еврокомиссии по вопросам готовности к чрезвычайным ситуациям в сфере здравоохранения и реагирования на них (HERA).
Подписывайтесь на наш Тelegram-канал t.me/sudua и на Google Новости SUD.UA, а также на нашу страницу в Facebook и в Instagram, чтобы быть в курсе самых важных событий.








































